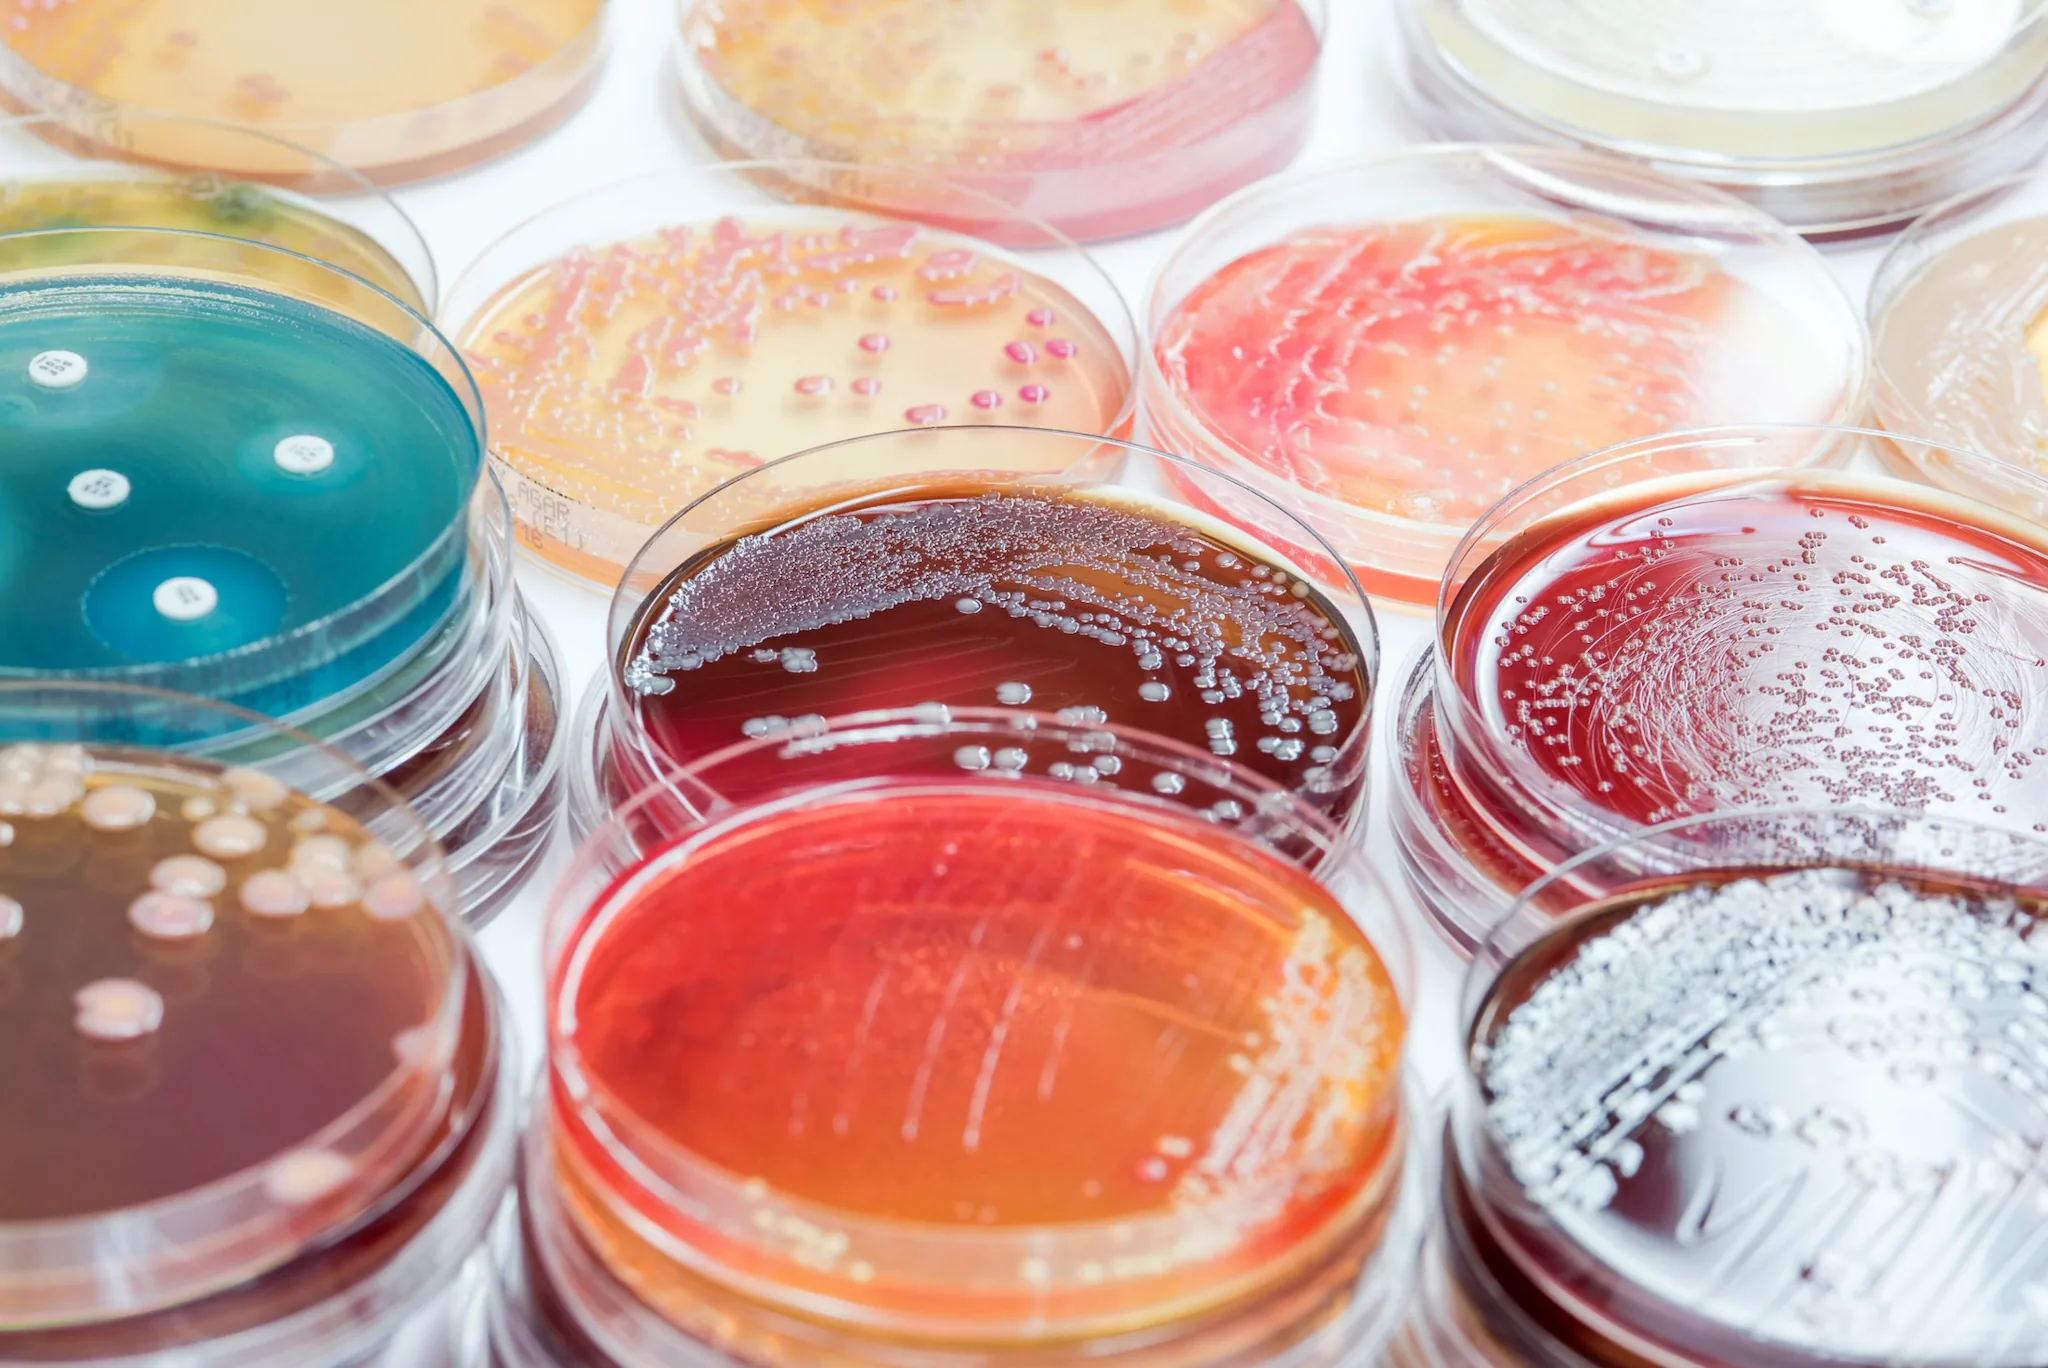
futuristic coronavirus cells abstract background

National Healthcare Safety Network (NHSN)
CDC’s National Healthcare Safety Network is the nation’s most widely used healthcare-associated infection tracking system. NHSN provides facilities, states, regions, and the nation with data needed to identify problem areas, measure progress of prevention efforts, and ultimately eliminate healthcare-associated infections.
In addition, NHSN allows healthcare facilities to track blood safety errors and important healthcare process measures such as healthcare personnel influenza vaccine status and infection control adherence rates.
- 2024 Patient Safety Component Manual [PDF – 8 MB]
- 2023 Patient Safety Component Manual [PDF – 8 MB]
- 2020 Long-term Care Facility Manual [PDF – 3 MB]
- 2024 Outpatient Procedure Component Manual [PDF – 1 MB]
- 2023 Outpatient Procedure Component Manual [PDF – 1,002 KB]
- 2020 Healthcare Personnel Safety Component Manual [PDF – 1 MB]
- 2021 Biovigilance Component Protocol [PDF – 600 KB]
To receive NHSN’s quarterly newsletter, enter your email address.